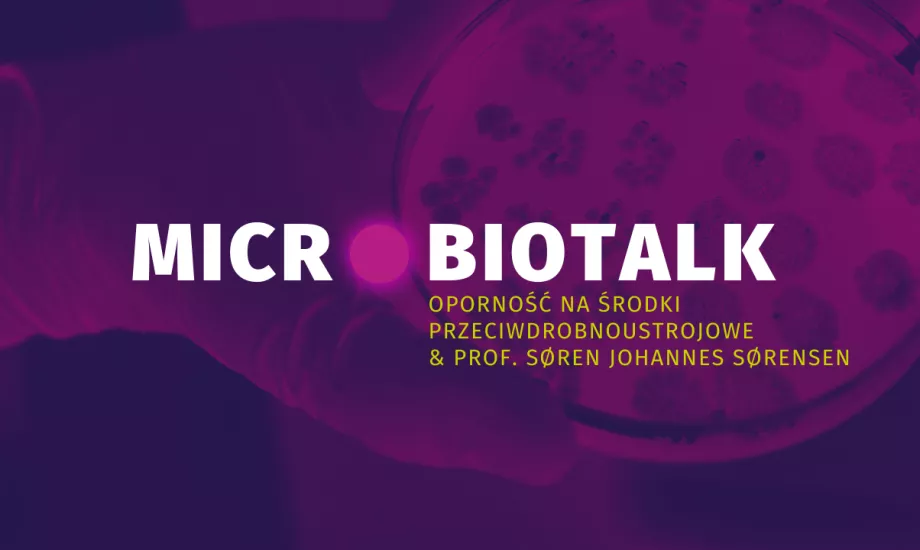
Wideo prof. Søren Johannes Sørensen na temat oporności na antybiotyki i mikrobioty jelitowej noworodka.

Microbiotalk:konferencje o oporności na środki antymikrobowe
Przerwać milczenie: globalna rozmowa o oporności na środki przeciwdrobnoustrojowe
Oporność na środki przeciwdrobnoustrojowe (AMR) to cicha pandemia zagrażająca dziesięcioleciom postępu medycyny. Konferencja Microbiotalk ma na celu rzucić światło na wielowymiarowe wyzwania związane z AMR, badając złożone powiązania między mikrobiotą jelitową, czynnikami środowiskowymi a zdrowiem publicznym. Z udziałem międzynarodowych ekspertów i przedstawicieli pacjentów, wydarzenie poruszy tematy takie jak wpływ antybiotyków na mikrobiotę jelitową, pojawianie się oporności we wczesnym dzieciństwie, środowiskowe rezerwuary bakterii opornych oraz kluczową rolę zaangażowania pacjentów i społeczeństwa.
Poprzez promowanie otwartego dialogu i dzielenie się najnowszymi badaniami, konferencja ta daje pracownikom ochrony zdrowia, decydentom i obywatelom narzędzia do podejmowania świadomych działań wobec jednego z najpoważniejszych zagrożeń zdrowotnych naszych czasów.
- Dowiedz się wszystkiego o mikrobiocie
- Mikrobiota i powiązane z nią zaburzenia
- Zadbaj o swoją mikrobiotę
- Publikacje
- O Instytucie
Dostęp do pracowników służby zdrowia
Znajdź tutaj swoją dedykowaną przestrzeńen_sources_title
en_sources_text_start en_sources_text_end
Sekcje

O tym artykule

Vanessa Carter
Zaangażowanie pacjentów i społeczeństwa jest kluczowe w walce z opornością na środki przeciwdrobnoustrojowe (AMR)

"Oporność na antybiotyki nie jest wystarczająco omawiana z pacjentami, a wielu z nich nie rozumie podstaw. Ucząc ludzi właściwego stosowania antybiotyków, możemy dać im możliwość bycia częścią rozwiązania."
Przewodnicząca Grupy Zadaniowej WHO ds. Ocalałych z AMR. Została rzeczniczką pacjentów z AMR w 2013 roku po przeżyciu poważnego wypadku samochodowego i 10-letniej rekonstrukcji twarzy, która spowodowała wysoce oporną infekcję MRSA, z którą walczyła przez 3 lata
Więc to było to, co nazywam moim... Albo jakie było moje ostatnie zdjęcie, które zostało zrobione w wieku 25 lat. Po prawej stronie znajduje się moja mama, zdjęcie naszych trzech pokoleń, moja babcia i ja.
Niedługo potem uległem wypadkowi samochodowemu w Johannesburgu w RPA. Samochód wyprzedził nas po złej stronie drogi. Wpadliśmy w gwałtowny korkociąg i uderzyliśmy w ścianę.
Zostałem reanimowany na miejscu i zostałem zabrany do Szpitala Akademickiego Charlotte Maxeke w Johannesburgu, gdzie zostałem podłączony do aparatury podtrzymującej życie, i miałem liczne obrażenia brzucha, szyi, pleców, a także miednicy i wiele złamanych kości po prawej stronie twarzy. Straciłem też prawe oko. Kiedy więc zostałam wypisana ze szpitala, czekała mnie dziewięcioletnia podróż, aby zrekonstruować moją twarz, ponieważ był to bardzo skomplikowany obszar i miał wiele uszkodzeń. To jest w zasadzie migawka tego, jak wyglądała moja podróż. Musiałem więc wszczepić wiele protez.
Na mojej czwartej protezie, którą trzeba było wszczepić około sześć lat później, po wypisaniu ze szpitala po operacji, poszedłem na zakupy. Opuściłem lusterko wsteczne i zobaczyłem, że ta wydzielina po prostu wydobywa się z mojej twarzy. Tak się przestraszyłam, że zadzwoniłam do mojego chirurga plastycznego, a on powiedział: "To wygląda na to, że to może być infekcja. Musimy zrobić pilną operację", co zrobiliśmy. Zostałem wypisany ze szpitala.
Dwa tygodnie później infekcja powróciła. Przeszli bardzo podobną operację. Musieli oczyścić protezę i przeprowadzić operację rekonstrukcyjną. Zostałem wypisany ze szpitala. Ale dwa tygodnie później infekcja wróciła, wyglądając gorzej. Zostałem wtedy przyjęty na drenaż zatok, ponieważ nie byłem tylko pod opieką chirurga plastycznego, ale miałem multidyscyplinarny zespół. Musiałam też skonsultować się z laryngologiem, z chirurgiem szczękowo-twarzowym, z chirurgiem plastycznym, z okulistą. Każdy z nich wyrażał różne opinie i przepisywał antybiotyki w międzyczasie, kiedy spotykałem się z nimi wszystkimi. I oczywiście, jak już mówiłem, miałem te trwające operacje, podczas których infekcja pojawiała się ponownie za każdym razem dwa tygodnie. W końcu prawie nie została mi twarz.
Jedenaście miesięcy po tym, jak po raz pierwszy zobaczyłem tę infekcję i kiedy ta infekcja powróciła cztery razy, zjadła dużo tkanki i musieli usunąć protezę w nagłych wypadkach. A mój chirurg plastyczny wysłał go do badań. To był pierwszy raz, kiedy usłyszałem słowo "test". Zadzwoniłem więc do biura patologii i powiedziałem: "Proszę, czy mogę zobaczyć kopię tego dokumentu, aby zrozumieć, co się dzieje?" A kiedy mi to wysłali, było dużo R, było około czterech lub pięciu S, co oznaczało, że byłem... Jestem pewien, że większość z was pracuje w mikrobiologii.
Oznaczało to, że byłem albo oporny, albo podatny na różne antybiotyki, które były po lewej stronie. Miałem też wysoce lekooporny MRSA, oporne na metycylinę zakażenie Staphylococcus aureus. Moi lekarze zrezygnowali ze mnie, ponieważ to było po prostu zbyt wiele szkodliwych skutków. Poza tym miałem też problem z infekcją, będąc pacjentem wysokiego ryzyka, z powrotem infekcji.
Zebrałem wywiad medyczny. Musiałem skontaktować się z około 25 chirurgami za granicą, ponieważ w Johannesburgu, w RPA, brakowało mi lekarza, którego potrzebowałem. Skontaktowałem się z lekarzem w Brigham and Women's Hospital w Bostonie, który przez 30 minut rozmawiał ze mną przez Skype'a i udzielił mi wskazówek, co powinienem zrobić, czyli przeciąć kość i unikać kolejnych ciał obcych. Nie mogliśmy zrobić operacji plastycznej. Najpierw musieliśmy zrobić operację szczękowo-twarzową. Powiedział: "A teraz posłuchaj tej rady i idź do lekarza w Johannesburgu, który dokładnie naśladuje to, co powiedziałem, co też uczyniłem".
Po kilku wizytach znalazłem lekarza. Możesz go zobaczyć w prawym dolnym rogu. Nazywał się profesor Reyneke i to on przeprowadził operację, która wyglądała niesamowicie. Nie mogliśmy uwierzyć, że pozbyliśmy się tego deficytu. Czułem, że było to warte całego tego trudu. Ponieważ od momentu wyjęcia protezy do momentu, w którym mogliśmy ją naprawić, minął w zasadzie rok.
Ale jak w przypadku déjà vu, infekcja powróciła. Tym razem nie tylko w skórze, ale także w kościach. Miałem zapalenie kości i szpiku, a także rozwinęła się u mnie alergia na miejscowy środek przeciwbakteryjny, który stosowali na skórze. W tym momencie możesz sobie wyobrazić, że moje serce zamarło, całkowicie straciłem nadzieję, ponieważ nie walczyłem z tą oporną infekcją.
Ale profesor Reyneke w zasadzie zaczął stosować antybiotyki ostatniej szansy. Więc trzymał mnie na jednym przez dwa tygodnie, przez 10 dni, musiałem wrócić, a on to sprawdzał i kierował mnie na inny kurs w zależności od tego, jak na nich reagowałem.
A trzy miesiące później, po wykonaniu tej czynności, wszystko zaczęło się znowu przejaśniać. Potem, prawdopodobnie około dwa tygodnie później, wylądowałem w szpitalu z adhezyjną niedrożnością jelit. Mój żołądek, myślę, że od tego całego stosowania tych antybiotyków,
Skończyło się na tym, że usunięto mi część jelit. Miałam też problemy ze zrostami, ale oczywiście antybiotyki nie pomagały w tej sytuacji. Po przejściu przez to, oto jaki był wynik.
Znowu dziewięć lat, niecałe 10 lat walki z tym wszystkim. I oczywiście w sumie trzy lata spędzone na walce z opornymi infekcjami. Kiedy już to zrobiliśmy, a nie umieściłem tutaj wszystkich moich slajdów, ale jednym z powodów, z których byłem bardzo sfrustrowany, było to, że nie była to powszechna wiedza. Dlaczego oporność na antybiotyki nie była omawiana ze mną jako pacjentem?
Od tego czasu wykonałem dużo pracy. Jedną z rzeczy, które zrobiłem ostatnio, jest założenie organizacji charytatywnej o nazwie AMR Narrative, która koncentruje się na rozwoju zdolności rzeczniczych i podnoszeniu świadomości, koncentrując się głównie na pacjentach i społeczeństwie. Oczywiście, pracujemy w czterech różnych sektorach, o czym przed chwilą mówili moi koledzy, w jednej perspektywie zdrowotnej.
Jest to przykład jednego z programów szkoleniowych, który przeprowadziliśmy niedawno w Brukseli we współpracy z Europejskim Forum Pacjentów. W rzeczywistości uczymy pacjentów podstaw oporności na antybiotyki, ponieważ te rozmowy nadal się nie toczą. To konkretne zdjęcie przedstawia 30 młodych rzeczników praw pacjentów z przewlekłymi schorzeniami, którzy chcą zacząć działać na rzecz oporności na środki przeciwdrobnoustrojowe w swoich regionach. Oto kilka zdjęć, z których właśnie wróciłem... Biorę udział w wielu wydarzeniach, ale jest kilka takich, które odbyły się podczas Zgromadzenia Ogólnego ONZ, o których opowiem trochę w dyskusji panelowej za chwilę, gdzie otworzyłem spotkanie wielu zainteresowanych stron wraz z Zastępcą Generalnym Organizacji Narodów Zjednoczonych i Prezydentem Zgromadzenia Ogólnego. Bardzo, bardzo ważna jest ta deklaracja polityczna, nad którą właśnie pracowali. Opowiem o tym za chwilę.
Oto niektóre z naszych narzędzi i zasobów z organizacji charytatywnej. Jeśli wejdziesz na naszą stronę internetową, będziesz mógł zobaczyć ich całkiem sporo. Stworzyliśmy również film dla pacjentów i opinii publicznej, aby dowiedzieć się nieco więcej w kategoriach laika, ponieważ jest to bardzo naukowy temat. Naszym głównym celem jest, aby była ona zrozumiała dla wszystkich. I to by było na tyle. W ten sposób dotrzesz do nas w mediach społecznościowych.
Dziękuję bardzo.
3 kluczowe przesłania
-
Zmagania z oporną infekcją: Vanessa Carter podzieliła się swoim osobistym doświadczeniem w walce z infekcją gronkowca złocistego opornego na metycylinę (MRSA), która wymagała wielu operacji i leczenia antybiotykami przez okres dziewięciu lat po wypadku samochodowym.
-
Znaczenie świadomości na temat oporności na antybiotyki: Podkreśliła brak komunikacji i świadomości na temat oporności na antybiotyki (AMR) wśród pacjentów, co zmotywowało ją do założenia organizacji charytatywnej, AMR Narrative, mającej na celu edukację i podnoszenie świadomości wśród społeczeństwa i pacjentów na ten kluczowy temat.
-
Wielodyscyplinarna i międzynarodowa współpraca: Vanessa podkreśliła znaczenie współpracy między różnymi specjalistami medycznymi oraz poszukiwania międzynarodowych porad w leczeniu jej skomplikowanej infekcji, ilustrując potrzebę globalnego i skoordynowanego podejścia w zarządzaniu opornymi infekcjami.
Pobierz jej prezentację (w języku angielskim)

Pr. Etienne Ruppé
Mikrobiota jelitowa i oporność na antybiotyki

"Pracownicy służby zdrowia muszą jasno komunikować pacjentom kwestie oporności na antybiotyki, ponieważ nieporozumienia nadal występują. Powinniśmy skupić się na szerszym środowisku, zamiast obwiniać mikrobiotę za oporność."
Jego badania koncentrują się na oporności na antybiotyki, interakcjach między mikrobiotą a pojawieniem się opornych bakterii, dynamice genów oporności na antybiotyki (resistom) oraz diagnostyce infekcji, ze szczególnym uwzględnieniem zastosowania nowych narzędzi sekwencjonowania.
Mikrobiota jelitowa i oporność na antybiotyki:
Bardzo dziękuję za zaproszenie i tę wspaniałą konferencję, którą dziś organizujecie. Tytuł mojego wystąpienia jest sednem tego, co dziś proponujesz, a mikrobiota jelitowa jest podstawą oporności na antybiotyki.
Zacznijmy od bardzo uproszczonego przedstawienia mikrobioty jelitowej i opornych bakterii, które mogą być w niej żywicielem. Myślę, że mikrobiota jelitowa zawiera ogromną liczbę różnych mikroorganizmów, z których dominującym są bakterie. Mamy setki gatunków, które szacujemy, a większość z nich to komensalne, ścisłe bakterie beztlenowe, które hodujemy z wielkim trudem w laboratorium, a większość z nich w ogóle nie hodujemy. Następnie pojawiły się oportunistyczne patogeny, takie jak enterobacterales, enterokoki i są one subdominujące w mikrobiocie jelitowej z powodu tego, co nazywamy efektem bariery lub opornością na kolonizację. Ta presja wywierana przez bakterie beztlenowe na ten oportunistyczny patogen ma bardzo ważną właściwość i zobaczymy, że kiedy bierzemy antybiotyki, po prostu zaburzamy tę równowagę.
Kiedy jesteśmy nosicielami opornych bakterii, o których będziemy dzisiaj mówić, to są one nawet subdominujące w swojej oportunistycznej populacji patogenów. Jesteśmy tu dzisiaj, ponieważ oporność na antybiotyki jest poważnym problemem, a od kilku lat wiemy, że zabija ona wielu ludzi na świecie. Szacujemy, że liczba zgonów wynosi około miliona rocznie. Jeśli nic nie zrobimy, jeśli nie zareagujemy, w ciągu najbliższych 30 lat może dojść do śmierci około 40 milionów osób.
Na tym wykresie widać głównych zabójców. Chcę tutaj podkreślić, że głównie połowa z nich to enterobacterales, Acinetobacter baumannii, Pseudomonas aeruginosa, połowa z nich. Myślę, że większość problemu oporności na antybiotyki leży obecnie w tych bakteriach.
Wtedy możesz również zobaczyć małe kółka z kolorami. Są to patogeny, w przypadku których WHO twierdzi, że istnieje krytycznie wysokie lub średnie zapotrzebowanie na nowe antybiotyki.
Potem mamy tutaj te małe emotikony kupy, które wskazują, że przed wywołaniem infekcji bakterie te leżą w jelitach. Będą kolonizować mikrobiotę jelitową, zanim wywołają infekcje. Właśnie dlatego mikrobiota jelitowa jest tak naprawdę podstawą oporności na antybiotyki.
Jeśli uda nam się kontrolować, zrozumieć, co dzieje się w mikrobiocie jelitowej, będziemy mieli wpływ na walkę z opornymi bakteriami. Oczywiście, jest to ładna równowaga, ten efekt bariery dla odporności na kolonizację.
Ale co, jeśli weźmiemy antybiotyki?
Wtedy zaburzamy tę równowagę, przechodzimy od zróżnicowanej bogatej mikrobioty do czegoś mniej zróżnicowanego, mniej bogatego. Oczywiście nie wszystkie antybiotyki wywierają taki sam wpływ na mikrobiotę. To zależy od tego, ile są wydalane w jelitach, jak szerokie jest ich spektrum. W zależności od tych zmiennych dochodzi do zaburzenia mikrobioty.
Jeśli jesteś już nosicielem opornych bakterii, będą się one rozszerzać. Sprzyjają również implantacji i kolonizacji nowych opornych bakterii. A to ma swoje konsekwencje.
Tak więc to, co dzieje się w jelitach, ma zewnętrzne konsekwencje. My i inni wykazaliśmy, że im więcej opornych bakterii nosisz w jelitach, tym bardziej będziesz narażony na infekcje wywołane przez te oporne bakterie, takie jak infekcje dróg moczowych, translokacja bakteryjna, szczególnie u pacjentów z neutropenią.
Będziesz rozprzestrzeniać się bardziej w środowisku, a to jest ważne. Jeśli znajdujesz się w strukturze opieki zdrowotnej, będzie to sprzyjać przenoszeniu się wirusa na innych pacjentów. Będziesz go nosić przez dłuższy czas, jest to nawet związane z zapaleniem płuc. Istnieje związek między jelitami a zapaleniem płuc u pacjentów na oddziale intensywnej terapii, gdzie zapalenie płuc ostatecznie zostaje skolonizowane w gardle przez oporne bakterie z jelit.
Te komensale, które mieliśmy z bakteriami beztlenowymi, nie są pozbawione genów oporności na antybiotyki (ARG). Różnią się one po prostu od opornych genów przenoszonych przez patogeny.
Kilka lat temu, kiedy pracowałem w IAME pod Paryżem, scharakteryzowaliśmy ten ludzki opór z trzewi. Zobaczysz, że jest bardzo zróżnicowana i zawiera ponad 6000 odpornych genów. My, wszyscy na tej sali, nosimy średnio 1000 opornych genów w naszych jelitach. Mają bardzo niską tożsamość z odpornymi genami, które znamy z patogenów. Są one w większości chromosomalne. I przy tych wszystkich kłótniach, zaczęliśmy myśleć, że może nie są takie złe, bo naprawdę trudno jest je przenieść na patogeny. Chodzi mi o to, że chcemy, aby nasze bakterie komensalne były odporne na antybiotyki. Więc może oporność na antybiotyki nie jest taka zła w zależności od rodzaju bakterii.
To była moja krótka prezentacja wprowadzająca kilka tematów na dziś. Chciałem podkreślić, że mikrobiota jelitowa składa się głównie z bakterii beztlenowych, w których dominujące są oportunistyczne patogeny. Większość bakterii, które powodują największy problem pod względem oporności na antybiotyki, ma rezerwuar jelitowy przed wywołaniem infekcji. Kiedy przyjmujemy antybiotyki, sprzyjamy ekspansji tej bakterii w jelitach, a to prowadzi do konsekwencji klinicznych. Nie zapomnijmy o naszych dobrych bakteriach, o naszych dobrych komensalach. Mają wiele opornych genów i nie są one w dużej mierze przenoszone na patogeny bakteryjne.
Z tym bardzo dziękuję
3 kluczowe przesłania
-
Rola mikrobioty jelitowej w oporności na antybiotyki: Mikrobiota jelitowa, która obejmuje ogromną różnorodność mikroorganizmów, odgrywa kluczową rolę w nosicielstwie zarówno bakterii komensalnych, jak i oportunistycznych patogenów. Równowaga w tej mikrobiocie jest niezbędna do zapobiegania nadmiernemu wzrostowi opornych bakterii.
-
Wpływ antybiotyków na mikrobiotę i oporność: Stosowanie antybiotyków zakłóca równowagę mikrobioty jelitowej, zmniejszając jej różnorodność i pozwalając na rozwój opornych bakterii. To zakłócenie może prowadzić do zwiększonego ryzyka infekcji, rozprzestrzeniania się w środowisku i przenoszenia krzyżowego w placówkach opieki zdrowotnej.
-
Znaczenie zrozumienia i zachowania bakterii komensalnych: Chociaż bakterie komensalne w jelitach przenoszą wiele genów oporności na antybiotyki, geny te nie są łatwo przenoszone na patogeny. Utrzymanie zdrowej populacji tych bakterii komensalnych jest kluczowe, ponieważ odgrywają one rolę ochronną, a ich oporność na ogół nie jest szkodliwa.
Pobierz jej prezentację (w języku angielskim)

Pr. Søren Johannes Sørensen
Oporność na antybiotyki i mikrobiom jelitowy niemowląt
"Dzieci często leczone antybiotykami od wczesnego wieku noszą więcej genów oporności na antybiotyki, zwłaszcza E. coli, a oporność jest wpływana przez antybiotyki przyjmowane przez ich matki, co wpływa na zdrowie długoterminowe."
Łączenie resistomu wczesnego życia z dojrzewaniem mikrobiomu. Jego badania koncentrują się na interakcjach społecznych w populacjach drobnoustrojów oraz ocenie zakresu przepływu genetycznego w naturalnych społecznościach i ich reakcji na zakłócenia środowiskowe.
Oporność na antybiotyki i mikrobiom jelitowy niemowląt:
Bardzo dziękuję za to wprowadzenie i za możliwość porozmawiania z Państwem dzisiaj.
Myślę, że podejmujemy działania, a właściwie nasze badania są w dużej mierze zgodne z tym, co właśnie usłyszeliśmy, ponieważ badaliśmy kohortę duńskich dzieci.
Właściwie nie tyle ze względu na początek tych badań mających na celu zrozumienie oporności na antybiotyki, ale byliśmy zainteresowani zrozumieniem, w jaki sposób mikrobiom we wczesnym okresie życia faktycznie kształtuje zdrowie w późniejszym okresie, a szczególnie w tym przypadku, patrząc na astmę, alergie i tego rodzaju choroby.
Już we wczesnym okresie życia badaliśmy mikrobiom, a potem zaobserwowaliśmy wyniki, że duża oporność na antybiotyki znajduje się w rezerwuarze mikrobiomu jelitowego dorosłych.
Byliśmy ciekawi, jak wcześnie zostanie to ustalone?
Czy jest to coś, co nabywamy w późnym wieku?
Albo jeśli już patrzymy na te dzieci?
Właściwie obserwowaliśmy te dzieci od urodzenia. Dane, na które patrzyliśmy, pochodziły z czasów, gdy dzieci były w wieku 1 roku, co zamierzam przedstawić.
Pytanie, które mieliśmy, brzmiało: czy duńskie dzieci w wieku jednego roku są już oporne na antybiotyki? A smutna, krótka odpowiedź brzmi: tak, jest.
Już wtedy jest tego całkiem sporo. To, co znaleźliśmy, co było dla nas zaskakujące, to na dole wykresu widać rozkład dzieci i liczbę genów oporności na antybiotyki. Tak więc niektóre dzieci nie mają wielu genów oporności na antybiotyki, podczas gdy w rzeczywistości inna populacja dzieci ma ich dużo. Nie tylko mieli wiele różnych typów genów oporności na antybiotyki, ale także mieli je w większej obfitości.
Dzieci zostały podzielone na dwie grupy. Dlatego byliśmy ciekawi, co tak naprawdę decyduje o tym, co tak naprawdę decyduje o tym, czy dziecko ma dużą oporność na antybiotyki, czy nie tak wiele. Ponieważ śledziliśmy tę kohortę bardzo, bardzo uważnie, mając wiele danych, mogliśmy spróbować przyjrzeć się niektórym z tych rzeczy.
Tak więc krąg wokół tego miejsca to w pewnym sensie te wszystkie metadane, które mamy, a jeden z nich może być przyczyną. Nie dziwi nas jednak to, że jeśli dzieci otrzymywały antybiotyki na leczenie, często we wczesnym okresie życia, na przykład w celu leczenia chorób dróg oddechowych, to istniało znacznie większe ryzyko, że znajdą się w grupie dzieci o dużej oporności na antybiotyki. Był to bardzo wyraźny związek. Odkryliśmy również, że jeśli te dzieci są matkami w czasie ciąży, mają teraz rok i przyjmowały antybiotyki, to dziecko rok później było znacznie bardziej narażone na dużą oporność na antybiotyki w porównaniu z mniejszą liczbą dzieci.
Nawet matki przyjmujące antybiotyki w czasie ciąży wydają się być dla tego bardzo ważne. Znaleźliśmy również inne korelacje, które są być może mniej oczywiste. Osoby mieszkające na obszarach miejskich są bardziej narażone na oporność na antybiotyki w porównaniu z osobami mieszkającymi na obszarach wiejskich.
Jeśli masz w domu zwierzę domowe, ryzyko wystąpienia oporności na antybiotyki jest mniejsze, więc czynników jest wiele. Staje się to coraz bardziej skomplikowane, ale zauważyliśmy bardzo wyraźną, nie tak zaskakującą rzecz.
Jeśli przyjmujesz antybiotyki, Twoje dziecko jest znacznie bardziej zagrożone. W rzeczywistości widzimy, że wiele antybiotyków jest przepisywanych dzieciom. Jeśli jednak spojrzysz na prawą stronę, zobaczysz diagram pokazujący, na jakie antybiotyki są oporne. Czerwone to antybiotyki faktycznie przepisane matce lub dziecku. Widzimy jednak dwie dominujące te, te, wobec których napotykamy największy opór, nigdy nie zostały przepisane ani dziecku, ani matce.
Ma to na celu pokazanie, że te rzeczy są trudniejsze do zrozumienia, niż często widzimy.
Staraliśmy się więc dokładniej to zbadać. Pomyśleliśmy, że jednym z wyjaśnień tego może być to, że mamy do czynienia z koselekcją. Wiemy często, że oporność na antybiotyki nie jest osamotniona. W rzeczywistości znajduje się w genomie razem z innymi opornościami na antybiotyki.
Zaczęliśmy sprawdzać, czy obserwujemy koselekcję. To właśnie pokazuje ten wykres. Prawdopodobnie jest to dla was bardzo trudne do zobaczenia, ale odkryliśmy bardzo wyraźnie, że dwa bardzo liczne geny oporności na antybiotyki są zlokalizowane razem z opornością na antybiotyki, którą są leczone. Widzimy, że kiedy podajemy jeden antybiotyk i właściwie nie ma znaczenia, który, powoduje to połączenie całego pakietu genów oporności na antybiotyki.
Kiedy przyjrzeliśmy się bliżej koselekcji, aby zobaczyć nie tylko, jakie oporności na antybiotyki znaleziono razem, ale także dlaczego były one również razem z innymi genami, odkryliśmy, że dość często były one ze zjadliwymi genami. W rzeczywistości, kiedy selekcjonujesz antybiotykooporność za pomocą antybiotyków, bakterie nie tylko stają się oporne na antybiotyki, ale także stają się gorszym patogenem. W tym samym czasie nabywają geny, które czynią je bardziej trwałym i zjadliwym patogenem. Wreszcie, zaobserwowaliśmy, że były one również zlokalizowane w tym samym miejscu, co geny mobilne.
To, co bakterie mogą zrobić, co jest fantastyczne, gdy się nad tym zastanowić, to możliwość wymiany genów między sobą. Jeśli bakteria spotka inną bakterię i powie: "Och, podoba mi się twój kolor oczu", może go zmienić i wtedy mają ten sam kolor.
Oczywiście nie mają oczu, ale mają geny oporności na antybiotyki, więc mogą wymieniać cechy z jednej bakterii na drugą. A te są dość często ruchomym elementem genetycznym. Wykazaliśmy bardzo wyraźnie, że oporność na antybiotyki siedzi u tych dzieci razem w dużych pakietach na ruchomych elementach genetycznych, aby mogły wymieniać ją w jelitach między tymi czy innymi bakteriami.
Więc nawet jeśli nie jest to potencjalnie chorobotwórczy bakter w jelitach dzieci, może jeśli dostaną bakterie chorobotwórcze, mogą je tam nabyć. Ale nie tylko to, mam na myśli, kiedy myślimy o prawdopodobieństwie, a jeśli jest to bakteria dróg oddechowych, być może nigdy nie dostanie się do jelit. Rzecz jednak w tym, że bakterie jelitowe nie zawsze znajdują się w jelitach.
Każdy z nas, także dzieci, tak naprawdę chodzi do toalety kilka razy dziennie. Tak więc bakterie jelitowe faktycznie opuszczają jelita. Są spłukiwane w toalecie. Jest to ważne zjawisko, które musimy zbadać.
3 kluczowe przesłania
-
Wczesne ustanowienie oporności na antybiotyki u dzieci: Badania na duńskich dzieciach pokazują, że oporność na antybiotyki może być ustanowiona już w wieku jednego roku. Dzieci narażone na antybiotyki we wczesnym okresie życia lub których matki przyjmowały antybiotyki w czasie ciąży, są bardziej narażone na noszenie dużej liczby genów oporności na antybiotyki.
-
Czynniki wpływające na oporność na antybiotyki: Różne czynniki wpływają na obecność oporności na antybiotyki u dzieci, w tym życie w mieście, stosowanie antybiotyków, a nawet posiadanie zwierząt domowych. Badanie wykazało, że dzieci w obszarach miejskich miały wyższą oporność, podczas gdy życie na wsi lub posiadanie zwierząt domowych wiązało się z niższą opornością.
-
Współselekcja i wymiana genów między bakteriami: Geny oporności na antybiotyki są często zlokalizowane razem z innymi genami oporności i wirulencji na ruchomych elementach genetycznych. Pozwala to bakteriom na wymianę tych genów, zwiększając ryzyko rozprzestrzeniania się oporności i czyniąc patogeny bardziej wirulentnymi.
Pobierz jej prezentację (w języku angielskim)
Antybiotyki: jaki wpływ na mikrobiotę i nasze zdrowie?

Elitsa Penkova
Oporność na środki przeciwdrobnoustrojowe w rzekach - zagrożenie dla zdrowia publicznego?

"Antybiotyki, które przyjmujemy, trafiają do odpadów, zanieczyszczając rzeki opornymi bakteriami, co wpływa na zdrowie publiczne, na przykład na dzikich pływaków."
Elitsa Penkova jest doktorantką na Uniwersytecie w Exeter, koncentrującą się na ocenie zagrożeń zdrowotnych związanych z narażeniem na oporność na środki przeciwdrobnoustrojowe (AMR) w środowiskach słodkowodnych. Jej badania szczegółowo badają, w jaki sposób pływacy w rzekach mogą być narażeni na bakterie i geny oporne na antybiotyki, mając na celu zrozumienie potencjalnych implikacji zdrowotnych związanych z przenoszeniem AMR przez naturalne środowiska słodkowodne.
Oporność na środki przeciwdrobnoustrojowe w rzekach - zagrożenie dla zdrowia publicznego?:
Dziękuję za wprowadzenie i dziękuję za zaproszenie. Być może zastanawiasz się, co ma wspólnego oporność na środki przeciwdrobnoustrojowe z rzekami? To jest problem szpitala, prawda? Ale dla ludzi takich jak ja, którzy badają oporność na antybiotyki, te środowiska są szczególnie interesujące, ponieważ zawierają już wszystkie niezbędne składniki do ewolucji oporności, aby zebrać się w jednym miejscu, o czym już wspominali niektórzy z naszych prelegentów.
Po pierwsze, w rzekach mamy bakterie środowiskowe, a większość z nich nie jest uważana za szkodliwą dla zdrowia publicznego. Niektóre z nich mogą być, oczywiście, ale większość z nich jest zaangażowana w takie rzeczy, jak obieg składników odżywczych i są po prostu normalną częścią ekosystemu środowiskowego.
Ale powodem, dla którego są tak interesujące, jest to, że mają różne mechanizmy oporu. Dzieje się tak dlatego, że przez ponad tysiąc lat miały czas na współistnienie z różnymi typami mikroorganizmów, które wytwarzają cząsteczki antybiotyków. A mikroorganizmy wytwarzają te cząsteczki, aby komunikować się ze sobą lub walczyć ze sobą. Aby móc współistnieć z tymi drobnoustrojami, które wytwarzają cząsteczki antybiotyków, bakterie środowiskowe musiały dostosować się i wyewoluować różne strategie radzenia sobie lub mechanizmy oporności.
Prawdziwym problemem jest to, kiedy te mechanizmy odporności stają się zbywalne, ponieważ w przeciwieństwie do ludzi, którzy mogą przekazywać geny tylko od rodzica do naszego potomstwa, bakterie mogą w rzeczywistości dzielić geny zarówno między gatunkami spokrewnionymi, jak i niespokrewnionymi.
Chociaż to naprawdę fascynujące widzieć, jak mogą dosłownie dzielić gen z jednej komórki do drugiej w poprzednim wykładzie, jest to również naprawdę przerażające, ponieważ oznacza, że gdy pojawi się mechanizm oporności i stanie się on przenoszalny, ma to potencjał do bardzo szybkiego rozprzestrzeniania się w obrębie i między populacjami bakterii.
W ten sposób bakterie są w stanie gromadzić wiele opornych genów w tym samym czasie, w ten sposób przechodzimy od opornej bakterii do tego, co nazywamy superbakterią. A tutaj zamieściłem przykład zdolności do dzielenia się genami między bakteriami środowiskowymi a klinicznie ważnymi patogenami.
Przykład dotyczy beta-laktamów. Przepraszam, oporność na beta-laktamy. Beta-laktamy to klasa antybiotyków, które są najczęściej stosowane na świecie w mechanizmie oporności, który bakterie wykorzystują do przezwyciężenia toksyczności tych antybiotyków, czyli oporności na beta-laktamy. Oporność na beta-laktamy to enzymy, które wiążą się z antybiotykiem i zasadniczo go rozkładają. Uważa się jednak, że geny kodujące te enzymy pierwotnie wyewoluowały w bakteriach środowiskowych i dopiero później przenoszą się do klinicznie ważnych patogenów.
A to tylko po to, aby zilustrować, że chociaż bakterie środowiskowe niekoniecznie stanowią zagrożenie dla zdrowia publicznego, mogą służyć jako rezerwuar dla klinicznie ważnych patogenów, które, nawiasem mówiąc, znajdują się również w rzekach. Tak więc za pomocą naszych odpadów stale wzbogacamy rzeki w innych naturalnych środowiskach słodkowodnych w bakterie związane zarówno z ludźmi, jak i zwierzętami, ale także w różne związki przeciwdrobnoustrojowe, w tym oczywiście antybiotyki.
Kiedy przyjmujemy antybiotyki, nie metabolizujemy ich w pełni, a większość z nich może być wydalana bezpośrednio do naszych toalet, a stamtąd odprowadzana do naszych systemów oczyszczania ścieków. Istnieją różne sposoby przetwarzania odpadów, ale żaden z nich nie jest przeznaczony specjalnie do usuwania genów oporności na antybiotyki lub związków przeciwdrobnoustrojowych. Niektóre z nich w końcu trafią do rzek.
Oprócz tego, oczywiście, coraz częściej słyszymy, że plany oczyszczania ścieków mogą faktycznie odprowadzać nieoczyszczone lub częściowo oczyszczone ścieki bezpośrednio do rzek podczas ulewnych deszczy. Ma to na celu zapobieżenie przeciążeniu i zapobieganie cofaniu się ścieków do domów, co jest w porządku. Ale tak naprawdę nie wiemy, co to oznacza dla rosnącej społeczności dzikich pływaków, na czym skupiają się moje badania.
W rzeczywistości bardzo mało uwagi poświęca się temu, jak narażenie na oporność na środki przeciwdrobnoustrojowe w tych środowiskach wpływa na zdrowie publiczne.
Wiemy z wcześniejszych prac w Norwegii, z badania kliniczno-kontrolnego, że pływanie w wodach słodkich zostało zidentyfikowane jako niezależny czynnik ryzyka nabycia opornych infekcji, opornych infekcji dróg moczowych.
Wiemy to również z badania przeprowadzonego w Norwegii, w którym oszacowano, że pływanie w słodkiej wodzie odpowiadało za około 6% przypadków nabycia opornych przypadków w społeczności w miesiącach letnich.
Wiemy to z badań przeprowadzonych na brytyjskich pływakach przybrzeżnych, a więc nie pływakach słodkowodnych, ale pływakach przybrzeżnych. Okazało się, że surferzy są czterokrotnie bardziej narażeni na przenoszenie bakterii opornych na antybiotyki niż ludzie, którzy nie wchodzą do wody.
Podobnie jak w tamtym badaniu, teraz staram się zrozumieć, czy pływacy słodkowodni są narażeni na wysokie ryzyko przenoszenia opornych bakterii w jelitach. Ale ponieważ wciąż zbieram próbki, nie jestem jeszcze w stanie opowiedzieć o moich odkryciach, ale chętnie odpowiem na wszelkie pytania, jeśli je masz.
Dziękuję
3 kluczowe przesłania
-
Rzeki jako rezerwuary oporności na antybiotyki: Rzeki zawierają bakterie środowiskowe, które przez tysiąclecia rozwinęły różnorodne mechanizmy oporności. Te bakterie mogą przenosić geny oporności na klinicznie istotne patogeny, co czyni rzeki znaczącymi rezerwuarami oporności na antybiotyki.
-
Wpływ ścieków na mikrobiotę rzek: Odpady ludzkie i zwierzęce, wraz ze związkami przeciwdrobnoustrojowymi, są ciągle wprowadzane do rzek poprzez ścieki. Oczyszczalnie ścieków nie są zaprojektowane do usuwania genów oporności na antybiotyki, co prowadzi do wzbogacenia rzek w te geny, zwłaszcza podczas intensywnych opadów, gdy nieoczyszczone ścieki są odprowadzane.
-
Zagrożenia zdrowia publicznego dla pływaków w wodach słodkich: Narażenie na bakterie oporne na antybiotyki w rzekach stanowi zagrożenie dla zdrowia publicznego, szczególnie dla pływaków w wodach słodkich. Badania wykazały, że pływanie w wodach słodkich może zwiększać ryzyko nabycia opornych infekcji, co podkreśla potrzebę dalszych badań nad wpływem oporności na środki przeciwdrobnoustrojowe w naturalnych środowiskach wodnych.
Pobierz jej prezentację (w języku angielskim)

Edith Odeh
Ampiclox i antykoncepcja, zwiększanie świadomości na temat AMR

"Podnoszenie świadomości na temat zdrowia reprodukcyjnego jest kluczowe w społecznościach, gdzie wiele kobiet jest źle poinformowanych. Wiedza daje siłę i poprawia społeczeństwo."
Pasjonatka i zaangażowana farmaceutka w Nigerii. Założycielka Kings Heritage Pharmaceutical Limited, Asaba, Nigeria.
Otworzyła centrum zdrowia, które gromadzi farmaceutów, lekarzy i wolontariuszy, aby dostarczać wiarygodnych informacji na temat metod antykoncepcyjnych oraz ostrzegać kobiety o długoterminowych konsekwencjach nadużywania antybiotyków, takich jak dysbioza mikrobioty i oporność na antybiotyki (AMR).
Ta ambicja przyniosła jej pierwszą nagrodę Henri Boulard w 2021 roku.
Zacznę od podzielenia się moimi wczesnymi inspiracjami i motywacją. W 2015 roku, na początku mojej kariery jako farmaceuty środowiskowej, pewnego pamiętnego dnia ojciec przyprowadził swoje 13-letnie dziecko, które cierpiało na ciężką biegunkę.
Tak więc po dokładnym zapoznaniu się z historią medyczną pacjenta zdecydowałem się na rozpoczęcie leczenia probiotykiem. W ciągu godziny od rozpoczęcia tej kuracji nastolatek, który przybył z wiadrem na odpady, był w stanie wygodnie opuścić aptekę ubrany tylko w pieluchę. To wspaniałe doświadczenie wzbudziło moje zainteresowanie zaangażowaniem firmy Biocodex w medycynę opartą na dowodach, inspirując mnie do opracowania projektu grantowego zatytułowanego "Ustanowienie ośrodka zdrowia reprodukcyjnego" w celu omówienia bezpiecznych metod antykoncepcji i obalenia mitów otaczających stosowanie kapsułki Ampiclox jako środka antykoncepcyjnego dla kobiet w Nigerii.
Być może zastanawiasz się, jaka jest korelacja między Saccharomyces a antykoncepcją? Wykazując się takim poziomem uczciwości i standardów, byłem przekonany, że ten instytut ma szczery cel i jeśli zasłużę na tę nagrodę, wygram.
Przejdźmy teraz do zakresu mojego projektu i realizacji. Projekt, który koncentrował się głównie na zdrowiu reprodukcyjnym i bezpiecznych metodach antykoncepcji, objął siedem społeczności, angażując średnio 20% populacji w każdej społeczności. Rozdaliśmy bezpłatne materiały edukacyjne dotyczące antykoncepcji oraz leki przeciwrobacze i inspirujące książki, aby zapewnić tym społecznościom dokładną wiedzę na temat reprodukcji i racjonalnego stosowania antybiotyków. Teraz, zdając sobie sprawę z wrażliwości kulturowej projektu, ściśle współpracowaliśmy z przywódcami społeczności, przywódcami religijnymi i pracownikami służby zdrowia, aby pilotować nasze podejście.
Doprowadziło to do imponującej frekwencji wynoszącej 20% we wszystkich społecznościach. Dzięki temu projektowi udało nam się zmniejszyć liczbę niechcianych ciąż, poprawić odpowiedzialne stosowanie antybiotyków i promować praktyki opieki zdrowotnej, wykorzystując lokalne partnerstwo. Udało nam się osiągnąć rezultat projektu i odpowiedzieć na konkretną potrzebę społeczności. W społeczności, w której około 50% populacji kobiet jest źle poinformowanych i naiwnych co do swojego zdrowia reprodukcyjnego, było to ogromne obciążenie.
Ale w wyniku tego projektu udało nam się je uwrażliwić i są teraz lepiej wyposażone w wiedzę reprodukcyjną. Mają lepszą kontrolę. To są niektóre ze zdjęć z tej akcji.
King's Heritage Pharma Limited planuje przeszkolić lokalnych przedstawicieli w każdej społeczności, którzy będą służyć jako ciągli edukatorzy i orędownicy zdrowia reprodukcyjnego. Naszym celem jest również rozszerzenie naszych działań na większą liczbę społeczności i budowanie silniejszego partnerstwa z pracownikami służby zdrowia. Zamierzamy również wzmocnić inicjatywę poprzez ściślejszą współpracę z lokalnymi influencerami.
Nasz ośrodek zdrowia reprodukcyjnego, który jest strategicznie zlokalizowany w Agbaroto-Otor, Ughelli, w stanie North Delta, będzie służył jako centrum wsparcia i edukacji. Teraz, gdy nadal rozszerzamy nasz zasięg i budujemy partnerstwo z pracownikami służby zdrowia w celu uzyskania trwałego wpływu, zapraszamy wszystkich pracowników służby zdrowia, liderów społeczności i edukatorów do przyłączenia się do nas w promowaniu zdrowia reprodukcyjnego i racjonalnego stosowania antybiotyków.
Dzięki Waszemu wsparciu i współpracy możemy wzmocnić pozycję większej liczby rzeczników, obalić szkodliwe mity i zapewnić zasoby, które zmienią życie. Razem możemy stworzyć zdrowszą, lepiej poinformowaną i bardziej odporną społeczność.
Dziękuję.
3 kluczowe przesłania
-
Inspiracja i zaangażowanie w medycynę opartą na dowodach: Wczesne doświadczenia Edith jako farmaceutki społecznej, skutecznie lecząc dziecko z ciężką biegunką za pomocą probiotyków, zainspirowały jej zaangażowanie w medycynę opartą na dowodach i doprowadziły do opracowania projektu grantowego skoncentrowanego na zdrowiu reprodukcyjnym i bezpiecznych metodach antykoncepcji w Nigerii.
-
Działania edukacyjne i informacyjne w społeczności: Projekt dotarł do siedmiu społeczności, angażując 20% populacji w każdej z nich, i dostarczył materiały edukacyjne na temat antykoncepcji i antybiotyków. Współpracując z liderami społeczności i pracownikami służby zdrowia, projekt skutecznie zmniejszył liczbę niechcianych ciąż i poprawił odpowiedzialne stosowanie antybiotyków.
-
Trwały wpływ i plany na przyszłość: Ośrodek zdrowia reprodukcyjnego w North Delta State, zbudowany dzięki otrzymanemu grantowi, będzie służył jako centrum wsparcia i edukacji, mając na celu budowanie silniejszych partnerstw i wzmacnianie społeczności poprzez dostarczanie dokładnej wiedzy na temat zdrowia reprodukcyjnego.
Pobierz jej prezentację (w języku angielskim)

Greatman Adiela Owhor
Projekt "100 Strażników AMR"

"Ten projekt miał na celu wzmocnienie pozycji profesjonalistów i opiekunów oraz wdrożenie solidnych inicjatyw dotyczących zarządzania antybiotykami w placówkach opieki zdrowotnej."
Greatman Adiela Owhor jest oddanym farmaceutą i twórcą treści zdrowotnych z solidnymi podstawami w badaniach, zarządzaniu projektami i promocji zdrowia. Jest wschodzącym badaczem z rosnącą wiedzą, który już opublikował w szanowanych czasopismach, takich jak The Lancet i International Journal of Health Planning and Management. Jego prace zdobyły ponad 150 cytowań i wskaźnik H równy 3, co odzwierciedla jego wpływ w tej dziedzinie.
Zaangażowanie Greatmana w zdrowie publiczne zostało szeroko uznane. W 2021 roku otrzymał prestiżową nagrodę Diany z Wielkiej Brytanii, wyróżnienie przyznawane młodym ludziom, którzy wnoszą znaczący wkład w swoje społeczności. Dodatkowo został nazwany "Farmaceutą Roku" w stanie Rivers w 2020 roku oraz "Promotorem Zdrowia Publicznego Roku" w 2021 roku. Jego praca została również doceniona podczas Światowego Dnia Wolontariatu w Nigerii (2020) za jego wkład w zdrowie publiczne.
W 2023 roku Greatman założył CommCase, przełomową platformę łączącą farmaceutów społecznych na całym świecie w celu rozwiązywania trudnych przypadków napotykanych w praktyce. CommCase umożliwiło rozwiązanie ponad 1000 przypadków w ciągu pierwszego roku, zdobywając szerokie uznanie w całej Afryce. Za swoją pracę z CommCase, Greatman został nazwany "Najlepszym Innowatorem Farmaceutycznym 2023 roku" w Nigerii przez Mega We Care Pharmaceuticals.
Wysiłki Greatmana w walce z opornością na środki przeciwdrobnoustrojowe (AMR) osiągnęły nowe szczyty w 2023 roku, kiedy otrzymał nagrodę Henri Boulard Public Health Award. Dzięki tej nagrodzie uruchomił ogólnokrajową kampanię świadomości AMR, która zaangażowała tysiące osób zarówno online, jak i offline, osiągając 50% wzrost świadomości w docelowych obszarach.
Z aktywną liczbą ponad 70 000 obserwujących na X (dawniej Twitter), Greatman nadal promuje zdrowie publiczne i zarządzanie AMR. Patrząc w przyszłość, zamierza wykorzystać promocję zdrowia i technologię, aby znacząco wpłynąć na zdrowie i dobrostan społeczności.
Nazywam się Greatman Adiela i jestem liderem zespołu w projekcie 100 AMR Stewards. Projekt ten miał na celu przede wszystkim umożliwienie 100 osobom przeprowadzenia lokalnych projektów dotyczących oporności na środki przeciwdrobnoustrojowe w ich regionie.
Realizacja tego projektu była możliwa dzięki wsparciu Fundacji Biocodex.
Zaczęliśmy więc od czteromiesięcznej kampanii internetowej, w ramach której dotarliśmy do ponad 600 000 Nigeryjczyków i rozmawialiśmy z nimi na temat kwestii związanych z opornością na środki przeciwdrobnoustrojowe w ich regionie.
W realizacji tego zaangażowania wykorzystaliśmy platformy takie jak Facebook, TikTok, Instagram, X i LinkedIn.
Szybko podjęto działania związane z poszukiwaniem stewardów, w liczbie 100 osób, szkoląc ich, pomagając im zrozumieć oporność na środki przeciwdrobnoustrojowe i problemy charakterystyczne dla ich środowiska, a także wspierając ich w realizacji lokalnego projektu.
Nigeria jest podzielona na sześć stref geopolitycznych, więc dbamy o to, aby nasi 100 stewardów było rozmieszczonych w tych strefach.
Po dwóch miesiącach zaczęliśmy się wzruszać, ponieważ stewardzi przesadzili ze swoim projektem. Cieszymy się, że udało nam się zrealizować projekty w rzeźniach, na targowiskach, w szkołach, a nawet na ulicach.
Zadbaliśmy o to, aby te projekty były mierzalne. W związku z tym stewardzi musieli dokonać jakiejś formy oceny, aby uzyskać liczby lub liczby dotyczące zrozumienia oporności na środki przeciwdrobnoustrojowe w ich regionie lub kwestii związanych z opornością na środki przeciwdrobnoustrojowe.
A następnie, po zakończeniu kampanii lub projektów, zostali również zmuszeni do ponownej oceny tych samych wskaźników, które były wcześniej oceniane, aby sprawdzić, czy nastąpiła poprawa. Cieszymy się, że niektóre regiony odnotowały ponad 70-procentowy wzrost wiedzy na temat oporności na środki przeciwdrobnoustrojowe.
Jesteśmy podekscytowani tym, co zrobiliśmy w ciągu ostatnich miesięcy, a jeszcze bardziej jesteśmy podekscytowani tym, że w przyszłości zrobimy więcej.
W imieniu wszystkich stewardów i mojego zespołu pragnę podziękować Fundacji Biocodex Microbiota Foundation za częściowe wsparcie tego projektu i urzeczywistnienie wszystkich naszych marzeń.
Dziękuję
3 kluczowe przesłania
-
Wzmocnienie i szkolenie strażników AMR: Projekt 100 Strażników AMR miał na celu wzmocnienie pozycji 100 osób w sześciu strefach geopolitycznych Nigerii do realizacji lokalnych projektów dotyczących oporności na środki przeciwdrobnoustrojowe (AMR). Ci strażnicy zostali przeszkoleni, aby zrozumieć problemy AMR specyficzne dla ich regionów i wspierani w realizacji mierzalnych lokalnych projektów.
-
Rozległe zaangażowanie online: Projekt rozpoczął się czteromiesięczną kampanią online, która dotarła do ponad 600 000 Nigeryjczyków za pośrednictwem platform takich jak Facebook, TikTok, Instagram, X i LinkedIn. Ta kampania zwiększyła świadomość na temat AMR i zaangażowała publiczność w związane z tym kwestie.
-
Znaczący wpływ i plany na przyszłość: Projekty strażników doprowadziły do ponad 70% wzrostu wiedzy na temat AMR w niektórych regionach. Sukces tych inicjatyw zmotywował zespół do kontynuowania rozszerzania swoich działań, z planami szkolenia większej liczby lokalnych przedstawicieli i budowania silniejszych partnerstw dla trwałego wpływu.
BMI-24.60